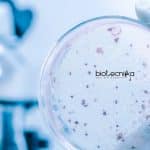
CSIR-IICB Microbiology Project Associate Vacancy Available CSIR-IICB Microbiology Project Associate

Home Search
biology - search results
If you're not happy with the results, please do another search
THSTI Biotech / Biochem & Biology Project Associate Recruitment
THSTI Vacancy - Biotech/Biochem & Biology Apply
THSTI Vacancy - Biotech/Biochem & Biology Apply. MSc Biotech/Biochme & Biology check out the details on the jobs...
NIT Durgapur Research Fellow Job – Biotech/Biochem & Microbiology Apply
NIT Durgapur Research Fellow Job - Biotech/Biochem & Microbiology Apply
NIT Durgapur Research Fellow Job - Biotech/Biochem & Microbiology Apply. Junior Research Fellow jobs for...
Syngene Stem Cell Biology Associate Scientist Jobs
Syngene Stem Cell Biology Associate Scientist Jobs
Syngene Stem Cell Biology Associate Scientist Jobs. Syngene MSc/MTech & MPhil Associate Scientist-Stem Cell Biology Jobs. Check the...
Pepsi Microbiology & Food Technology QC Manager Recruitment
Pepsi Microbiology & Food Technology QC Manager Recruitment
Pepsi Microbiology & Food Technology QC Manager Recruitment. PepsiCo India requires Food Technology to apply online for...
NIPGR Research Jobs For Life Science/Biotech/Biochem & Molecular Biology
NIPGR Research Jobs For Life Science/Biotech & Molecular Biology
NIPGR Research Jobs For Life Science/Biotech & Molecular Biology. PhD/MSc/MTech Life Science/ Biotech/Biochem & Molecular Biology...
CSIR-IICB Microbiology Project Associate Vacancy Available
CSIR-IICB Microbiology Project Associate Vacancy Available
CSIR-IICB Microbiology Project Associate Vacancy Available. MSc Microbiology/ Botany/ Zoology jobs for eligible candidates at CSIR-IICB. CSIR-IICB Jobs -...
Pfizer Microbiology Advisor Job Opening – Apply Online
Pfizer Microbiology Advisor Job Opening - Apply Online
Pfizer Microbiology Advisor Job Opening - Apply Online. Pfizer is hiring MSc Microbiology candidates for Medical Advisor,...
TERI Associate Jobs – Biotech / Life Science & Microbiology Apply
TERI Associate Jobs - Biotech / Life Science & Microbiology Apply
TERI Associate Jobs - Biotech / Life Science & Microbiology Apply. Interested and eligible...
Sun Pharma Biotech / Biology & Biochem Job Recruitment
Sun Pharma Job - Biotech / Biology & Biochem Vacancy
Sun Pharma Job - Biotech / Biology & Biochem Vacancy. Biotechnology, Biochemistry and Biology Sun...
Takeda Microbiology Quality Control Executive / Officer Job
Takeda Microbiology Quality Control Executive / Officer Job
Takeda Microbiology Quality Control Executive / Officer Job. Takeda Senior Officer/ Executive - Quality Control (Microbiology) Job...
NICED NACO Project Recruitment – Biotech/ Life Science/ Microbiology Apply
NICED Job For Life Science/Biotech & Microbiology Candidates
NICED Job For Life Science/Biotech & Microbiology Candidates. ICMR-National Institute of Cholera & Enteric Diseases recruiting for...
CSIR-CSMCRI Project Associate Jobs For Life Science/ Biotech/ Microbiology
CSMCRI Biotech Job - Life Science & Microbiology Apply
CSMCRI Biotech Job - Life Science & Microbiology Apply. MSc Biotech/Zoology/ Microbiology & Life Science Project...
Banaras Hindu University Molecular Biology Research Associate Job
BHU Molecular Biology Research Associate Job
BHU Molecular Biology Research Associate Job. BHU, Varanasi is hiring for research position. PhD Molecular Biology candidates are eligible...
TERI Project Associate Job For Biotech/Life Science & Microbiology
TERI Project Associate Job For Biotech/Life Science & Microbiology
TERI Project Associate Job For Biotech/Life Science & Microbiology. Interested and eligible candidates with MSc Biotech/Life...
Freshers Project Trainee For Biotech / Life Science / Microbiology at Vaxfarm Life Sciences
Freshers Biotech Jobs - Project Trainee Vacancy Available
Freshers Biotech Jobs - Project Trainee Vacancy Available. RCB is hiring msc/mtech biotechnology/ life science & microbiology...